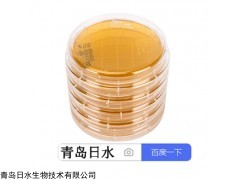
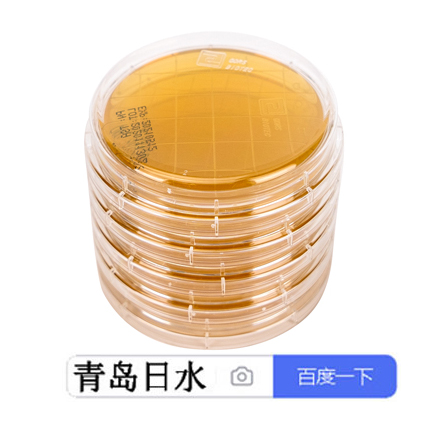

产品简介
胰酪大豆胨琼脂培养基(TSA)青岛日水55mm胰酪大豆胨琼脂培养基接触碟TSA生产标准——2020版《zhong国药典》中guo药典2020版培养基TSA青岛日水55mm胰酪大豆胨琼脂培养基接触碟TSA
产品说明
胰酪大豆胨琼脂培养基(TSA)
青岛日水55mm胰酪大豆胨琼脂培养基接触碟TSA
生产标准——2020版《zhong国药典》中guo药典2020版培养基TSA
包装规格——内容物15~20ml/个,55mm×10个/包,三层真空包装
产品用途——用于设备、车间、人员、包装材料等表面微生物的测定
组成成分——胰酪胨15g;大豆木瓜蛋白酶水解物5g;氯hua钠5g;琼脂15g……
青岛日水55mm胰酪大豆胨琼脂培养基接触碟TSA
贮藏条件——2-25℃避光保存
青岛日水55mm胰酪大豆胨琼脂培养基接触碟TSA
有效期限——180天
青岛日水55mm胰酪大豆胨琼脂培养基接触碟TSA
相关产品:
12723-1:胰酪大豆胨液体培养基TSB干粉已辐照日水生物
12724-1:胰酪大豆胨琼脂培养基TSA干粉已辐照日水生物
32724R-8:胰酪大豆胨琼脂培养基TSA+tou孢菌素酶50万日水生物

更多请搜索一下: 日水生物培养基
本页产品地址:http://www.geilan.com/sell/show-9257505.html

![]()
免责声明:以上所展示的[32724- 青岛日水55mm胰酪大豆胨琼脂培养基接触碟TSA]信息由会员[青岛日水生物技术有限公司]自行提供,内容的真实性、准确性和合法性由发布会员负责。
免责声明:以上所展示的[32724- 青岛日水55mm胰酪大豆胨琼脂培养基接触碟TSA]信息由会员[青岛日水生物技术有限公司]自行提供,内容的真实性、准确性和合法性由发布会员负责。